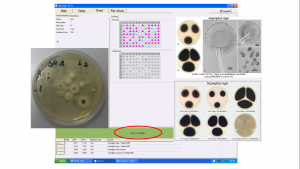

Obiectivele principale ale acestui studiu au urmărit investigarea incidenței micotoxinelor deoxinivalenol și zearalenonă în cereale pentru micul dejun prelevate din supermarketuri din București, utilizarea sistemului Biolog® pentru identificarea tulpinilor fungice izolate din eșantioanele prelevate și optimizarea metodei de detecție și cuantificare a micotoxinelor din cerealele pentru micul dejun utilizând metoda ELISA.
Au fost selectate 32 de probe de cereale, dintre care 19 de probe fabricate în România și 13 probe de cereale pentru micul dejun fabricate în Uniunea Europeană și în state partenere spațiului comunitar.
Probele de cereale pentru micul dejun eșantionate au cuprins:
- 7 eșantioane de fulgi pe porumb pentru micul dejun (din care: 6 probe fabricate în România; 2 probe fără zahăr adăugat dintre care 1 probă etichetată „produs fără zahăr”; 1 probă cu ingredient provenit din agricultura ecologică, etichetată „produs bio”; 1 probă etichetată „produs fără gluten”; 1 probă etichetată „produs ce nu conține organisme modificate genetic”);
- 4 eșantioane de müsli pentru micul dejun (din care: 3 probe fabricate în România; 3 probe cu adaos de fructe uscate; 2 probe fără adaos de zahăr, din care 1 probă etichetată „fără zahăr”);
- 8 eșantioane de fulgi pe cereale integrale pentru micul dejun (din care: 3 probe fabricate în România; 5 probe fabricate în UE; toate cele 8 probe conțin doar fulgi de cereale (3 probe de ovăz, 1 probă de grâu, 1 probă de orz, 2 probe de secară, 1 probă de hrișcă); 5 probe conțin cereale integrale (3 probe de ovăz, 1 probă de secară, 1 probă de grâu); 1 probă conține orez integral);
- 11 eșantioane de cereale pentru micul dejun cu adaos de vitamine (din care: 3 probe fabricate în România; 8 probe fabricate în UE; 4 probe cu adaos de cacao sau ciocolată);
- 2 eșantioane de grâu expandat (probe fabricate în România).
Nicio probă de cereale de mic dejun nu a prezentat mucegaiuri vizibile, însă, rezultatele parametrului microbiologic „drojdii și mucegaiuri” au înregistrat valori cuprinse între 9 x 102 ufc/g și 2,3 x 103 ufc/g, în timp ce limita maxim admisă conform Ordinului nr. 27/2011 al ANSVSA pentru matricea alimentară „derivate din cereale (fulgi de gâu, porumb, orez, produse expandate)” este de 1 x 102 ufc/g. Astfel, dintre cele cinci tipuri de produse de cereale pentru micul dejun selectate, respectiv fulgi de porumb, müsli cu adaos de fructe uscate, cereale integrale, cereale cu adaos de vitamine și grâu expandat, care au însumat un total de 32 de probe analizate, cinci probe au înregistrat prezența drojdiilor și mucegaiurilor, aceste eșantioane făcând parte din tipurile müsli cu adaos de fructe uscate (2 eșantioane), cereale cu adaos de vitamine (2 eșantioane) și cereale de grâu expandat (1 eșantion). Nivelul cel mai ridicat de drojdii și mucegaiuri a fost înregistrat de proba P21 (2,3 x 103 ufc/g), ce face parte din categoria cereale cu adaos de vitamine, urmată fiind de proba P20 (1,7 x 103 ufc/g), care face parte din aceeași categorie de produse.
Identificarea microorganismelor izolate din produsele alimentare studiate utilizând sistemul Biolog®, a indicat prezența în una din probele de cereale de tip müsli cu adaos de fructe uscate, a microorganismului producător de micotoxine Aspergillus niger (fig. 1.).
În ceea ce privește conținutul de micotoxine al probelor de cereale pentru micul dejun selectate, în urma detecției și cuantificării micotoxinelor, toate probele au înregistrat valori ale micotoxinelor deoxinivalenol, zearalenonă și ochratoxina A (fig. 2.) sub nivelurile maxim admise, conform REGULAMENTULUI (CE) NR. 1881/2006 AL COMISIEI din 19 decembrie 2006 de stabilire a nivelurilor maxime pentru anumiți contaminanți din produsele alimentare. Două probe au consemnat valori ale aflatoxinelor totale mai mari decât limita stabilită, respectiv 4,10 ppb și 4,05 ppb.

Dintre cele 32 de probe analizate, 4 eșantioane (12,50%) au înregistrat valori pozitive pentru micotoxina deoxinivalenol. Toate valorile, însă, au fost mai mici decât limita de cuantificare pentru această micotoxină. 20 de probe (62,50%) de cereale pentru micul dejun au înregistrat valori pozitive pentru ZEA. Toate cerealele de tip fulgi de porumb au notat valori pozitive pentru această micotoxină, nivelul maxim fiind consemnat de proba P6 (8,00 ppb). Toate produsele de tip cereale integrale și grâu expandat nu au indicat prezența zearalenonei. Micotoxina OTA a fost detectată doar în cazul a 2 eșantioane (6,25%). O singură probă, respectiv P21, care se încadrează în clasa de cereale pentru micul dejun cu adaos de vitamine, a notat absența micotoxinei AFLA. Valorile cele mai mari au fost consemnate de probe care fac parte din aceeași categorie de produse, menționată anterior. O singură probă analizată, care se încadrează în categoria cereale pentru micul dejun de tip müsli cu adaos de fructe uscate, a înregistrat valori pozitive pentru toate micotoxinele analizate. Nicio probă de cereale pentru micul dejun nu a înregistrat absența tuturor celor patru micotoxine analizate.
Prezentul studiu a fost realizat prin Programul-nucleu, derulat cu sprijinul MCI, contract nr. 29N/2016, proiect PN 16 46 04 02.
Autori:
Irina Smeu*, Elena Mirela Cucu, Alina Alexandra Dobre, Enuța Iorga
*Șef colectiv ELISA, laborator Microbiologie-ELISA
Institutul Național de Cercetare-Dezvoltare pentru Bioresurse Alimentare – IBA București

